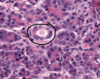

Lab 5 Flashcards
(148 cards)
Esophagus - musculares externa, submucosa, mucosa

Stomach mucosa- lamina propria, gastric pit, neck, gastric gland, muscularis mucosa

Small intestine - muscularis externa, intestinal glands, submucosa, muscularis mucosa, intestinal villi

Large intestine - muscularis externa, tenia coli

Esophagus – mucosa, submucosa, muscularis externa

Esophagus – mucosa – stratified squamous non-keratinized ep, lamina propria with small blood vessels, muscularis mucosa (smooth muscle)

Esophagus - submucosa (DICT) with blood vessels

Parietal (A) & Chief Cells (B) in Stomach

Fundic gland - lumina (L) of the fundic glands can be recognized. The chief cells (CC) are granular in appearance and are much smaller than the round, plate like parietal cells (PC). Parietal cells, so their name imply, are located at the periphery of the gland. Slender connective tissue elements (CT), housing blood vessels, occupy the narrow space between the closely packed glands.

Microvilli of the Duodenum - microvilli (curved arrows) of the duodenum. Each microvillus is covered with the plasma membrane which has an external glycocalyx of glycoproteins some of which function as enzymes that participate in the terminal digestion of proteins and carbohydrated. The central core of the microvilli is occupied by actin microfilaments and several actin binding proteins. Microfilaments from the microvilli extend into the apical cytoplasm to from part of the terminal web (TW).

Rectum -
rectum is the terminal portion of the sigmoid colon, and therefore, it is similar in structure to the colon. At the macroscopic level, this area has longitudinal folds called rectal columns. The mucosa contains numerous goblet cells, and the submucosa may have hemorrhoidal venous plexuses which can extend into the lamina propria. The mascularis externa has
both inner circular and outer longitudinal smooth muscle layers. Arrows: some of the blood channels.

Classic liver lobule

gallbladder

Pancreas

Pig liver -
liver is invested by a connective tissue capsule, Glisson’s capsule (GC), from which in the pig, septa (Se) extend to subdivide the gland into more
or less hexagon-shaped classical lobules (Lo). Blood vessels, lymph vessels, and bile ducts travel within the connective tissue septa to reach the apices of the classic lobules, which are known as the portal area (PA). Bile reaches the portal area from within the lobules, whereas blood enters the substance of the lobules from the portal areas. Within each lobule, the blood flows through tortuous channels, the liver sinusoids, to enter the central vein (CV) in the middle of the classical lobule.

Classical liver lobule - classical liver lobule (outlined by arrowheads) is defined by the arrangement of connective tissue in the portal tract (B) areas and has its centre at the central vein (A) or terminal hepatic venule. Hepatocytes radiate along blood sinusoids from the tracts to the central vein and bile flows in the opposite direction

Kupffer cells - system of macrophages, known as Kupffer cells (KC), are found interspersed among the endothelial lining cells of Liver sinusoids (Si). these macrophages are larger than the epithelial cells and may be recognized by the presence of phagocytosed material within them. Kupffer cells may be demonstrated by injecting an animal intravenously with indian ink, as in this specimen. Some cells appear as large black smudges because they are filled with phagocytosed ink (arrows), whereas other cells possess only small quantities of the phagocytosed material (arrow heads). Note that much of the sinusoidal lining devoid of ink, indicating that the endothelial cells are probably not phagocytic.

Bile canaliculi - hepatocyte cell membrane (arrowheads) are clearly evidence in this photomicrograph. Note that in fortuitous sections, bile canaliculi (arrows) are recognizable. These bile canaliculi are small intercellular spaces through which bile flows to the periphery of the lobule. Human Liver.

Bile canaliculi - Bile is secreted into bile canaliculi (BC). These channels are formed by the retraction of
the plasma membranes (arrows) of the hepatocytes to produce an open space between adjacent cells. Thus, bile canaliculi are not channels lined by a cell population distinct
from hypatocytes, but are an anastomosing series of tunnels lined y the hepatocytes themselves. Microvilli from the surface of the hepatocytes that form the bile canaliculus entre the channel. Tight junctions (arrowheads) between the hepatocytes seal off the area and prevent leakage of bile into the intercellular spaces.

Kidney

Kidney

Kidney

Empty bladder, full bladder

Kidney - medulla, cortex, collecting duct in middle, thin segment of loop of henle, ascending or descending loop of henle